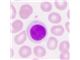
واردات محیط های کشت ۱۰۰ گرمی با سرتیفیکیت - هورمون های گیاهی

واردات محیط های کشت ۱۰۰ گرمی با سرتیفیکیت - هورمون های گیاهی
واردات و فروش محیط های کشت تخصصی در بسته بندی های ۱۰۰ و ۵۰۰ گرمی از کمپانی های معتبر اروپائی مرک - زیگما - آلدریچ - کیولب - لب کم موجود است - هورمون های گیاهی موجود است . واتساپ و همراه ۰۹۱۲۵۰۳۵۵۳۸
قیمت
- قیت همکار / عمده فروشی :
اطلاعات تامین کننده
رایان شیمی پارس
تهرانتولید کننده، وارد کننده، عمده فروش، خرده فروش، صادر کننده، خدمات
آون -شیکر - میکسر آزمایشگاهی ، انکوباتور ساده و یخچالدار، بن ماری آب و روغن ، هود شیمیائی و میکروبی ، سکوبندی آزمایشگاهی ، میکروسکوپ ساده و پلاریزان دو چشمیو سه چشمی ، ترازو و رطوبت سنج ، مواد شیمیائی مرک آلمان، محیط های کشت میکروبی مرک و کیو لب ، شیشه آلات آزمایشگاهی ، کجلدال و سوکسوله، میز ترازو
مشاهده سایت فروشندهخرید از تامین کنندگان برتر پارس سنتر!

تامین کنندگان برتر پارس سنتر سرعت پاسخگویی بالاتر و محصولات بروز تری نسبت به سایر تامین کنندگان دارند.
مشخصات
- محیط های کشت
- محیط کشت ۱۰۰ گرمی
توضیحات محصول
تجهیز ات آزمایشگاهی - واردات مواد شیمیائی مرک – مواد شیمیائی زیگما – مواد شیمیائی کره ای – انواع محیط های کشت 100 گرمی و محیط های کشت 500 گرمی مرک آلمان – -رنگ ها و معرف های آزمایشگاهی - انواع اسید ها و محلول ها – دستگاههای آزمایشگاهی –فور – انکوباتور- بن ماری – انواع ترازو – رطوبت سنج – هود شیمی – لامینار فلو (هود میکروبی ) – فیلتر های آزمایشگاهی – کاغذ صافی – فیلتر 45/0 استریل – فیلتر 22/0 استریل – اتوکلاو – سکوبندی های آزمایشگاهی – تجهیز کامل آزمایشگاه – تجهیزات تخصصی آزمایشگاه کارخانجات مواد غذائی – تجهیزات تخصصی دانشگاهها – تجهیزات تخصصی آزمایشگاههای داروسازی
هورمون های گیاهی
شرکت رایان شیمی با 30 سال سابقه در خصوص واردات تجهیزات آزمایشگاهی و فروش تجهیزات تخصصی آزمایشگاهها ائم از انواع مواد شیمیائی و دستگاههای آزمایشگاههای شیمی و میکروبیولوژی در خدمت جامعه آزمایشگاهی کشور میباشد .
تجهیزات تخصصی آزمایشگاههای کارخانجات مواد غذائی
دستگاههای تخصصی کارخانجات آرد : آنالایزر آرد – گلوتن شور – گلوتن گراف – بمبو – رطوبت سنج غلات – رطوبت سنج آرد – واردات انواع دستگاههای تخصصی کارخانجات آرد از کمپانی پرتنperten
دستگاههای تخصصی کارخانجات لبنیات – انواع رطوبت سنج – ترازو- سانترفیوز ژربر – آنالایزر یازده پارمتری شیر بلغاری – آنالایزر شیر ژربر آلمان – انواع بوتیرومتر ژربر – انواع دکانتور اسید – دکانتور الکل – کیت ها ی فسفاتاز – کیت کمبو – بتا استار – ورتکس – انواع بورت مخزن پلاستیکی – دیسپنسر ضد اسید آلمانی
دستگاههای تخصصی دیگر مانند انواع رنگ سنج از کمپانی لاوی باند- ویسکوزیمتر- میکرومتر های می تو تو یو ژاپن – اسپکتوفتومتر دبل بیم
شرکت رایان شیمی علاوه بر واردات اقلام آزمایشگاهی حدودا" ده سال است که اقدام به ساخت انواع دستگاههای ازمایشگاهی ائم از فور (اون) – انکوباتور دو درب – انکوباتور یخچالدار- هات پلیت مگنت – شیکر انکوباتور- شیکر لوله (ورتکس) - بن ماری آب – بن ماری روغن – هود شیمی – هود میکروبی (هود لامینار) – ژرمیناتور(اتاقک رشد) – سکوبندی آزمایشگاهی و.. با ابعاد و مشخصات درخواستی نموده است
• انواع میکروسکوپ از کمپانیNikon ژاپنOlympusآلمان...
• دستگاههای آب مقطر گیری با ظرفیت مختلف از کمپانی Hamilton وBB انگلستان وGFL آلمان
• انواع سانتریفیوژ ساخت کمپانی هایHettichآلمان وCentrionانگلستان و ....
• انواع ترازوهای حساس ساخت کمپانیSartoriusوKern آلمان وANDژاپن
• انواع رفرکتومترها از کمپانی Atagoژاپن و ....
• ارائه دستگاه های تخصصی صنایع لبنی از کمپانیFunk Gerberآلمان
• ارائه دستگاه رطوبت سنج مورد مصرف کارخانه های آرد و غلات و دیگر صنایع غذائی
• ارائه کلیه دستگاه های روتین آزمایشگاهی ساخته شده توسط شرکت های ایرانی
شیشه آلات و دیگر ملزومات فلزی و پلاستیکی آزمایشگاهی
• ارائه انواع شیشه آلات آزمایشگاهی کلاسA( ارلن ، بشر ، بالن ژوژه ، پیپت ، بورت...) کروزه ، بوتریمتر
دانسیتومتر ، ترمومتر ، هیدرومتر ، فیلتر ، سمپلر و ... از کمپانیIsolabوElmnoآلمان و دیگر کمپانی ها
تعمیر و سرویس کلیه دستگاه های آزمایشگاهی و ارائهUpsو استابیلایزر برق جهت رفع نوسانات برق
ارائه دستگاه اولتراسونیک فراری دهنده حیوانات موذی ( موشها) و انواع سموم دفع آفات و حشرات
خواهشمند است در صورت نیاز به هر گونه اطلاعات بیشتر و یا دریافت کاتالوگ دستگاه ها از تماس با ما دریغ نفرمائید.
پیشاپیش از حسن توجه و عنایتی که مبذول می دارید سپاسگذاریم.
شما عزیزان میتوانید با شماره های زیر تماس بگیرید و یا به وب سایت ما مراجعه فرمائید
تلفن : 22345521-22345522-22091837
تلفن ویژه : 22352206
تلفن : 22144680الی 83
همراه :09125035538
سامانه دریافت و ارسال پیامک 10009122788004
www.rsp-group.com
n.bolghari@rsp-group.com
از شما که در تمام این سالها در کنار ما بوده اید سپاسگذاریم
در شبکه های اجتماعی همراه ما باشید
https://www.instagram.com/rspgroupco/
https://t.me/Rayanshimipars